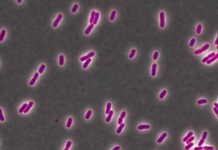
Research: Triclosan added to toothpaste, mouthwash to kill bacteria inadvertently makes such cells stronger —

Research: Diving into Earth’s interior helps scientists unravel secrets of diamond formation —
Understanding the global carbon cycle provides scientists with vital clues about the planet's habitability.
It's the reason why the Earth has a clement stable...
Research: A tasty Florida butterfly turns sour —
The viceroy butterfly is a mimic, modeling its orange-and-black colors after the queen butterfly, a bug that tastes so disgusting predators have learned...
Research: Wallace’s giant bee has been rediscovered in Indonesia —
An international team of scientists and conservationists has announced the finding of what many consider to be the 'holy grail' of bee discoveries...
Research: Triclosan added to toothpaste, mouthwash to kill bacteria inadvertently makes such cells stronger...
Grocery store aisles are stocked with products that promise to kill bacteria. People snap up those items to protect themselves from the germs...
Research: Many birds respond positively to the warmer climate conditions associated with drought —
How wildlife respond to climate change is likely to be complex. To better understand the effects of climate change on the bird community...
Research: Analysis reveals Caribbean communities that are most at risk from the social and...
Climate change has fueled coral reef bleaching throughout the tropics, with negative consequences for reef ecosystems and the people who depend on them....
Research: Yeasts reach across tree of life to domesticate suite of bacterial genes —
An insect's gut might seem an inhospitable place to settle in, but diverse microbes nonetheless make their home there. Yet in the gut,...
Research: Origins of giant extinct New Zealand bird traced to Africa —
Scientists have revealed the African origins of New Zealand's most mysterious giant flightless bird -- the now extinct adzebill -- showing that some...
Research: How bird feather patterns form —
Feathers evolved in dinosaurs and are a key characteristic of birds today. They are arranged in a precise hexagonal pattern in a bird's...
Research: Do volcanoes or an asteroid deserve blame for dinosaur extinction?
Based on new data published today in the journal Science, it seems increasingly likely that an asteroid or comet impact 66 million years...
Top News
Hey ISIS, You Suck: Local Muslims Post Anti-ISIS Billboard
A new billboard on Manchester Road in Missouri reads, "HEY ISIS, YOU SUCK!!! From: #ActualMuslims."
A group of Muslim-Americans have put up a blunt billboard...